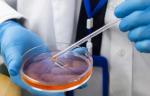
d6df6e52-341f-4350-bfa7-70ee983a826e.jpg

Университетская клиника Щитовидной Железы
Адрес:
Москва,
Молодогвардейская, д. 2, корп. 1, помещ. 2/1
Режим работы клиники:
Пн-Пт 08:00-20:00
Cб 08:00-16:00
Вс 08:00-16:00
Телефон для записи в клинику: +7 (495) 324-17-93
Университетская клиника щитовидной железы – специализированный консультативно-диагностический медицинский центр, предлагающий полный комплекс диагностики заболеваний щитовидной железы и эндокринной системы. В клинике можно сдать все необходимые анализы крови, включая тесты на гормоны, биохимию и другие важные показатели. Медицинский центр специализируется на биопсиях узловых образований для точного определения их характера, а также проводит такую инновационную процедуру, как термоабляция. Прием проводится по предварительной записи.